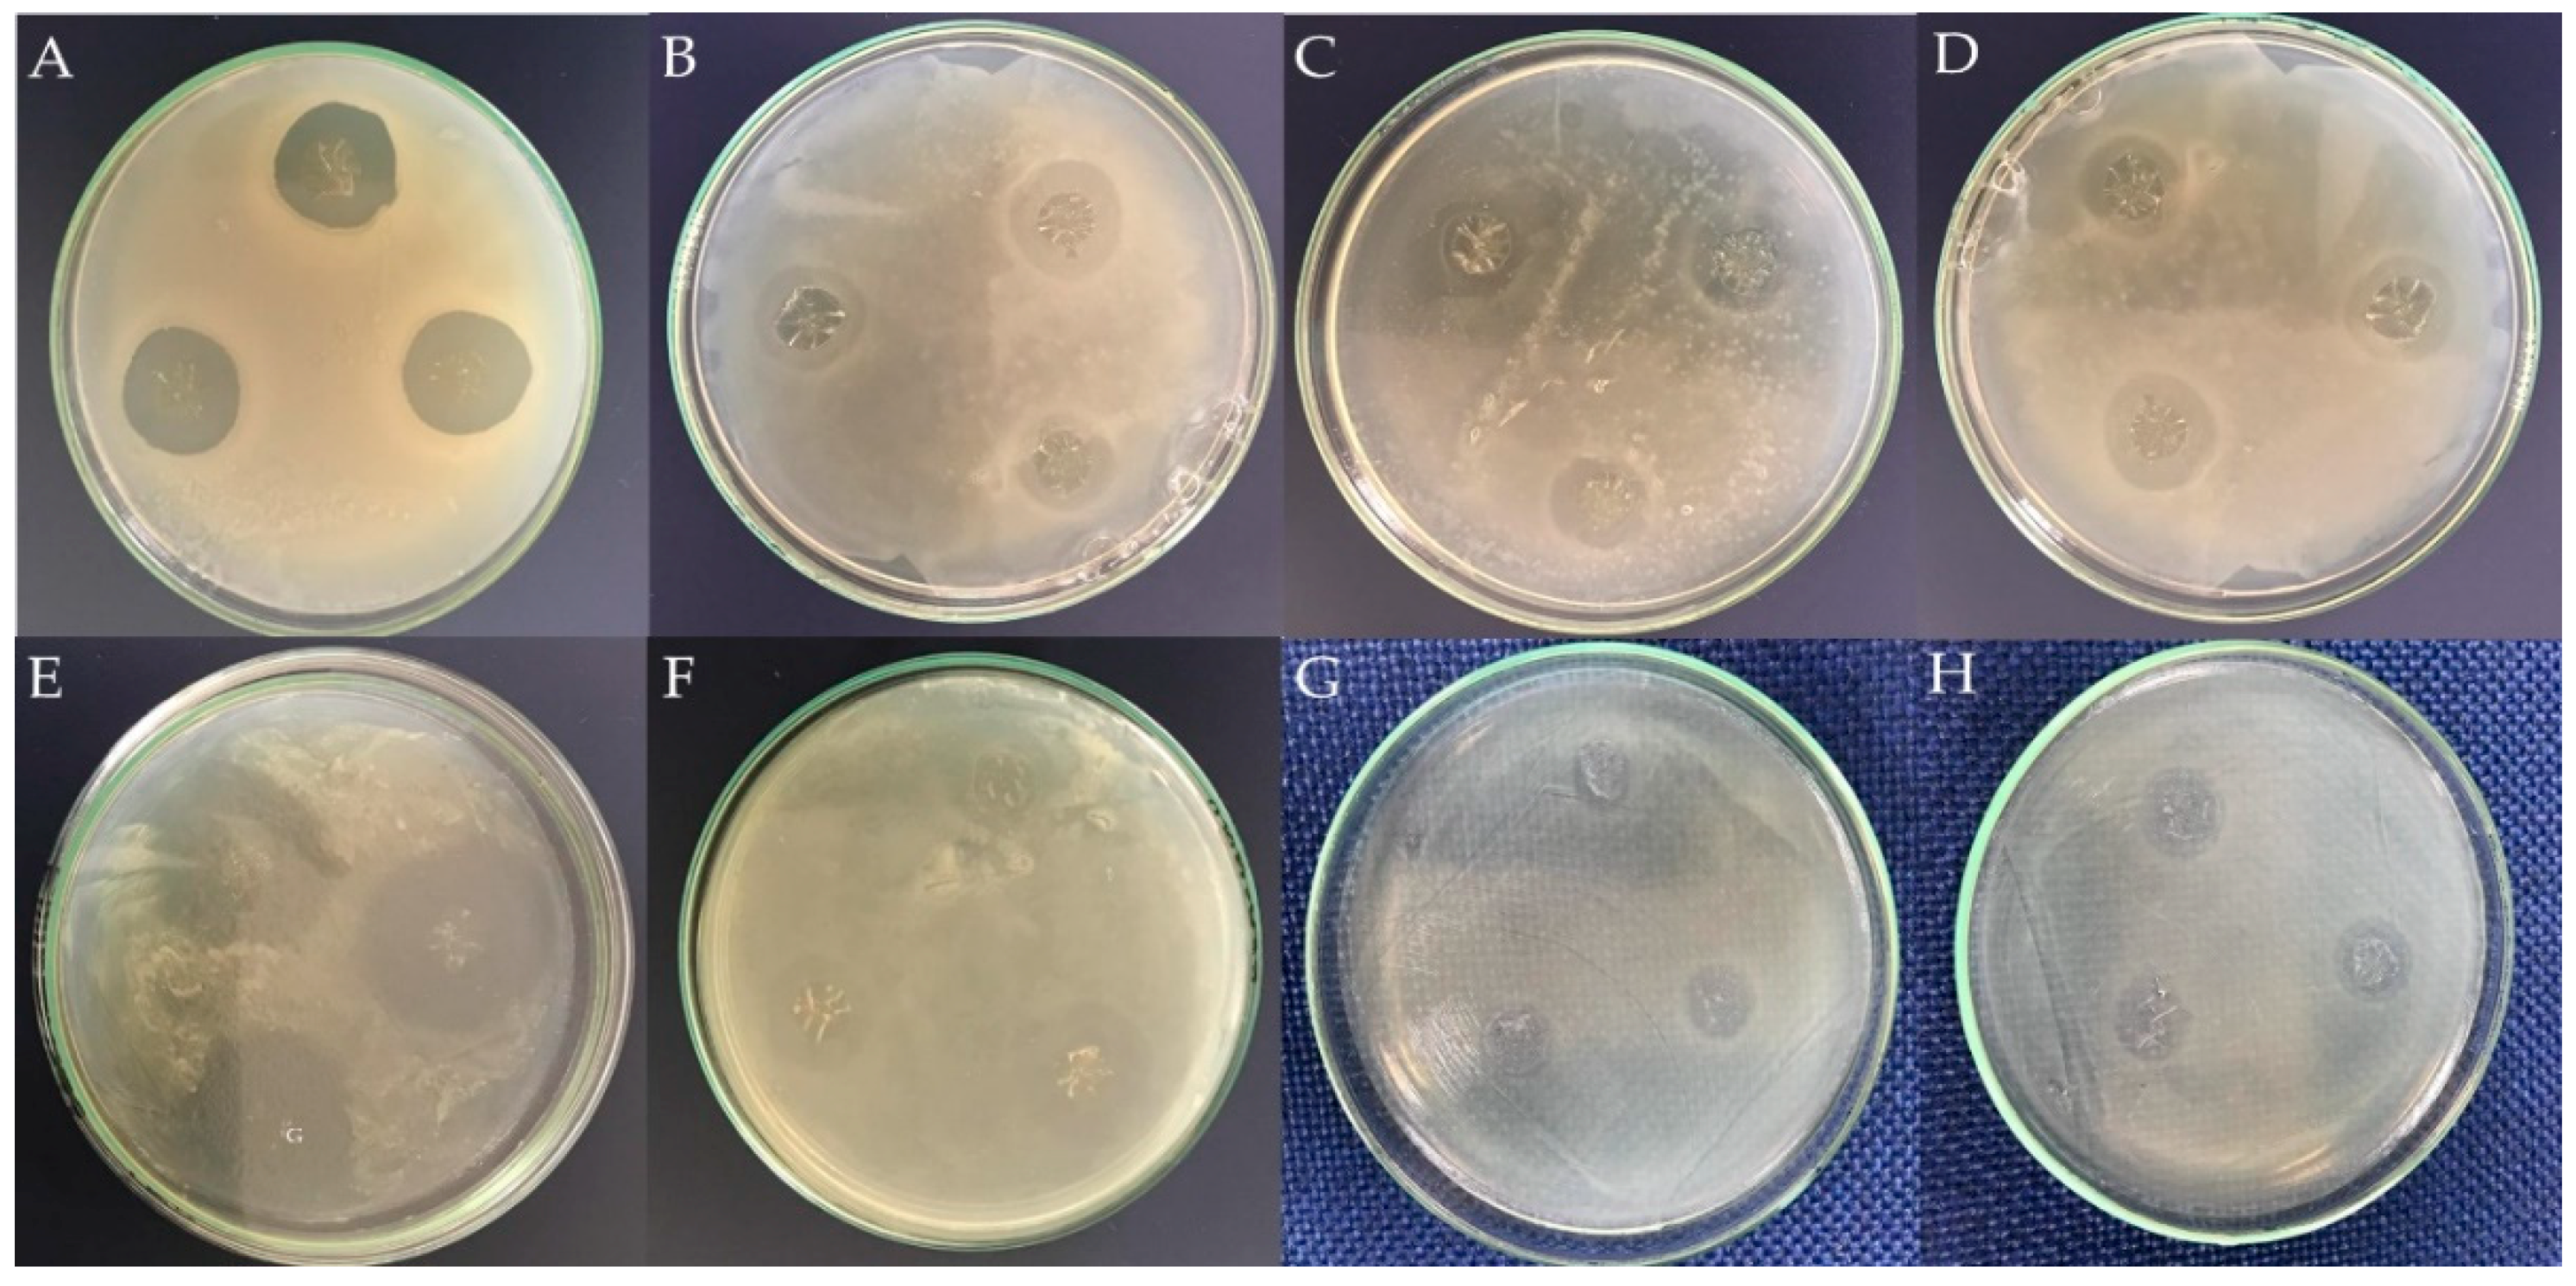

Synthesis and Characterization of a Bioartificial Polymeric System with Potential Antibacterial Activity: Chitosan-Polyvinyl Alcohol-Ampicillin
Abstract
1. Introduction
2. Results and Discussion
2.1. Fourier Transform Infrared (FTIR)
2.2. Scanning Electron Microscopy (SEM)
2.3. Differential Scanning Calorimetry (DSC)
2.4. Surface Wettability
2.5. Microbiological Testing
2.6. Antibiotic Release Studies
3. Materials and Methods
3.1. Sample Preparation
3.2. Fourier Transform Infrared (FTIR)
3.3. Scanning Electron Microscopy (SEM)
3.4. Differential Scanning Calorimetry (DSC)
3.5. Surface Wettability
3.6. Microbiological Tests
3.7. Antibiotic Release Studies
3.8. Statistical Analysis
4. Conclusions
Author Contributions
Funding
Acknowledgments
Conflicts of Interest
References
- Bernal, A.; Kuritka, I.; Saha, P. Preparation and characterization of poly(vinyl alcohol)-poly(vinyl pyrrolidone) blend: A biomaterial with latent medical applications. J. Appl. Polym. Sci. 2013, 127, 3560–3568. [Google Scholar] [CrossRef]
- Bernal, A.; Kuritka, I.; Kasparkova, V.; Saha, P. The effect of microwave irradiation on poly(vinyl alcohol) dissolved in ethylene glycol. J. Appl. Polym. Sci. 2013, 128, 175–180. [Google Scholar] [CrossRef]
- Bernal, A.; Balkova, R.; Kuritka, I.; Saha, P. Preparation and characterisation of a new double-sided bio-artificial material prepared by casting of poly(vinyl alcohol) on collagen. Polym. Bull. 2013, 70, 431–453. [Google Scholar] [CrossRef]
- Cascone, M.G. Dynamic-mechanical properties of bioartificial polymeric materials. Polym. Int. 1997, 43, 55–69. [Google Scholar] [CrossRef]
- Luckachan, G.E.; Pillai, C.K.S. Biodegradable Polymers—A Review on Recent Trends and Emerging Perspectives. J. Polym. Environ. 2011, 19, 637–676. [Google Scholar] [CrossRef]
- Sionkowska, A.; Płanecka, A.; Kozłowska, J.; Skopińska-Wiśniewska, J. Photochemical stability of poly(vinyl alcohol) in the presence of collagen. Polym. Degrad. Stab. 2009, 94, 383–388. [Google Scholar] [CrossRef]
- Jagur-Grodzinski, J. Biomedical application of functional polymers. React. Funct. Polym. 1999, 39, 99–138. [Google Scholar] [CrossRef]
- Langer, R.; Tirrell, D.A. Designing materials for biology and medicine. Nature 2004, 428, 487–492. [Google Scholar] [CrossRef] [PubMed]
- Lazzeri, L. Progress in bioartificial polymeric materials. Trends Polym. Sci. 1996, 8, 249–252. [Google Scholar]
- Wong, S.-S.; Altinkaya, S.A.; Mallapragada, S.K. Crystallization of poly (vinyl alcohol) during solvent removal: Infrared characterization and mathematical modeling. J. Polym. Sci. Part. B Polym. Phys. 2007, 45, 930–935. [Google Scholar] [CrossRef]
- Sionkowska, A. Current research on the blends of natural and synthetic polymers as new biomaterials: Review. Prog. Polym. Sci. 2011, 36, 1254–1276. [Google Scholar] [CrossRef]
- Mano, V.; Ribeiro e Silva, M.E.S. Bioartificial polymeric materials based on collagen and poly(N-isopropylacrylamide). Mater. Res. 2007, 10, 165–170. [Google Scholar] [CrossRef]
- Scotchford, C.A.; Cascone, M.G.; Downes, S.; Giusti, P. Osteoblast responses to collagen-PVA bioartificial polymers in vitro: The effects of cross-linking method and collagen content. Biomaterials 1998, 19, 1–11. [Google Scholar] [CrossRef]
- Vasheghani, F.B.; Rajabi, F.H.; Ahmadi, M.H. Influence of solvent on thermodynamic parameters and stability of some multicomponent polymer complexes involving an acrylic polymer, poly (ethylene imine) and poly (vinyl pyrrolidone). Polym. Bull. 2007, 58, 553–563. [Google Scholar] [CrossRef]
- Ahmad, S.I.; Hasan, N.; Zainul Abid, C.K.V.; Mazumdar, N. Preparation and characterization of films based on crosslinked blends of gum acacia, polyvinylalcohol, and polyvinylpyrrolidone-iodine complex. J. Appl. Polym. Sci. 2008, 109, 775–781. [Google Scholar] [CrossRef]
- Merchan, M.; Sedlarikova, J.; Friedrich, M.; Sedlarik, V.; Sáha, P. Thermoplastic modification of medical grade polyvinyl chloride with various antibiotics: Effect of antibiotic chemical structure on mechanical, antibacterial properties, and release activity. Polym. Bull. 2011, 67, 997–1016. [Google Scholar] [CrossRef]
- Merchan, M.; Sedlarikova, J.; Sedlarik, V.; Machovsky, M.; Svobodová, J.; Sáha, P. Antibacterial polyvinyl chloride/antibiotic films: The effect of solvent on morphology, antibacterial activity, and release kinetics. J. Appl. Polym. Sci. 2010, 118, 2369–2378. [Google Scholar] [CrossRef]
- Goy, R.C.; de Britto, D.; Assis, O.B.G. A review of the antimicrobial activity of chitosan. Polimeros 2009, 19, 241–247. [Google Scholar] [CrossRef]
- Croisier, F.; Jérôme, C. Chitosan-based biomaterials for tissue engineering. Eur. Polym. J. 2013, 49, 780–792. [Google Scholar] [CrossRef]
- Kong, M.; Chen, X.G.; Xing, K.; Park, H.J. Antimicrobial properties of chitosan and mode of action: A state of the art review. Int. J. Food Microbiol. 2010, 144, 51–63. [Google Scholar] [CrossRef] [PubMed]
- Liang, S.; Liu, L.; Huang, Q.; Yam, K.L. Preparation of single or double-network chitosan/poly (vinyl alcohol) gel films through selectively cross-linking method. Carbohydr. Polym. 2009, 77, 718–724. [Google Scholar] [CrossRef]
- Sarasam, A.; Madihally, S. V Characterization of chitosan—Polycaprolactone blends for tissue engineering applications. Biomaterials 2005, 26, 5500–5508. [Google Scholar] [CrossRef] [PubMed]
- Suyatma, N.E.; Copinet, A.; Tighzert, L.; Coma, V. Mechanical and barrier properties of biodegradable films made from chitosan and poly (lactic acid) blends. J. Polym. Environ. 2004, 12, 1–6. [Google Scholar] [CrossRef]
- Martinez-Camacho, A.P.; Cortez-Rocha, M.O.; Ezquerra-Brauer, J.M.; Graciano-Verdugo, A.Z.; Rodriguez-Félix, F.; Castillo-Ortega, M.M.; Yépiz-Gómez, M.S.; Plascencia-Jatomea, M. Chitosan composite films: Thermal, structural, mechanical and antifungal properties. Carbohydr. Polym. 2010, 82, 305–315. [Google Scholar] [CrossRef]
- Kaczmarek, H.; Podgórski, A. The effect of UV-irradiation on poly (vinyl alcohol) composites with montmorillonite. J. Photochem. Photobiol. A Chem. 2007, 191, 209–215. [Google Scholar] [CrossRef]
- Ding, B.; Kim, H.-Y.; Lee, S.-C.; Lee, D.-R.; Choi, K.-J. Preparation and characterization of nanoscaled poly(vinyl alcohol) fibers via electrospinning. Fibers Polym. 2002, 3, 73–79. [Google Scholar] [CrossRef]
- Zhou, W.Y.; Guo, B.; Liu, M.; Liao, R.; Rabie, A.B.M.; Jia, D. Poly(vinyl alcohol)/Halloysite nanotubes bionanocomposite films: Properties and in vitro osteoblasts and fibroblasts response. J. Biomed. Mater. Res. Part A 2010, 93, 1574–1587. [Google Scholar] [CrossRef] [PubMed]
- Hajji, S.; Chaker, A.; Jridi, M.; Maalej, H.; Jellouli, K.; Boufi, S.; Nasri, M. Structural analysis, and antioxidant and antibacterial properties of chitosan-poly (vinyl alcohol) biodegradable films. Environ. Sci. Pollut. Res. 2016, 23, 15310–15320. [Google Scholar] [CrossRef] [PubMed]
- Pineda-Castillo, S.; Bernal-Ballén, A.; Bernal-López, C.; Segura-Puello, H.; Nieto-Mosquera, D.; Villamil-Ballesteros, A.; Muñoz-Forero, D.; Munster, L. Synthesis and Characterization of Poly (Vinyl Alcohol)-Chitosan-Hydroxyapatite Scaffolds: A Promising Alternative for Bone Tissue Regeneration. Molecules 2018, 23, 2414. [Google Scholar] [CrossRef] [PubMed]
- Raafat, D.; Sahl, H.-G. Chitosan and its antimicrobial potential—A critical literature survey. Microb. Biotechnol. 2009, 2, 186–201. [Google Scholar] [CrossRef] [PubMed]
- De Souza Costa-Júnior, E.; Pereira, M.M.; Mansur, H.S. Properties and biocompatibility of chitosan films modified by blending with PVA and chemically crosslinked. J. Mater. Sci. Mater. Med. 2009, 20, 553–561. [Google Scholar] [CrossRef] [PubMed]
- Mansur, H.S.; Costa, E.D.S.; Mansur, A.A.P.; Barbosa-Stancioli, E.F. Cytocompatibility evaluation in cell-culture systems of chemically crosslinked chitosan/PVA hydrogels. Mater. Sci. Eng. C 2009, 29, 1574–1583. [Google Scholar] [CrossRef]
- Mansur, H.S.; Sadahira, C.M.; Souza, A.N.; Mansur, A.A.P. FTIR spectroscopy characterization of poly (vinyl alcohol) hydrogel with different hydrolysis degree and chemically crosslinked with glutaraldehyde. Mater. Sci. Eng. C 2008, 28, 539–548. [Google Scholar] [CrossRef]
- Yang, J.M.; Su, W.Y.; Leu, T.L.; Yang, M.C. Evaluation of chitosan/PVA blended hydrogel membranes. J. Membr. Sci. 2004, 236, 39–51. [Google Scholar] [CrossRef]
- Holland, B.J.; Hay, J.N. The thermal degradation of poly(vinyl alcohol). Polymer 2001, 42, 6775–6783. [Google Scholar] [CrossRef]
- Finch, C.A. Polyvinyl Alcohol: Developments; Wiley: New York, NY, USA, 1992. [Google Scholar]
- Lambert, J.B.; Gronert, S.; Shurvell, H.F.; Lightner, D.; Cooks, R.G. Organic Structural Spectroscopy; Prentice Hall: New York, NY, USA, 2001. [Google Scholar]
- Tayyari, S.F.; Zahedi-Tabrizi, M.; Laleh, S.; Moosavi-Tekyeh, Z.; Rahemi, H.; Wang, Y.A. Structure and vibrational assignment of 3,4-diacetyl-2,5-hexanedione. A density functional theoretical study. J. Mol. Struct. 2007, 827, 176–187. [Google Scholar] [CrossRef]
- Wong, J.Y.; Bronzino, J.D. Biomaterials, 1st ed.; CRC Press: Boca Raton, FL, USA, 2007. [Google Scholar]
- Bhat, N.V.; Nate, M.M.; Kurup, M.B.; Bambole, V.A.; Sabharwal, S. Effect of γ-radiation on the structure and morphology of polyvinyl alcohol films. Nucl. Instrum. Methods Phys. Res. Sect. B Beam Interact. Mater. Atoms 2005, 237, 585–592. [Google Scholar] [CrossRef]
- Petrova, N.V.; Evtushenko, A.M.; Chikhacheva, I.P.; Zubov, V.P.; Kubrakova, I.V. Effect of microwave irradiation on the cross-linking of polyvinyl alcohol. Russ. J. Appl. Chem. 2005, 78, 1158–1161. [Google Scholar] [CrossRef]
- Natalia, V.A.; Evtushenko, A.M.; Chikhacheva, I.P.; Zubov, V.P.; Kubrakova, I. V Effect of microwave irradiation on the structuring of polyvinyl alcohol. Mendeleev Commun. 2005, 15, 170–172. [Google Scholar]
- Kumar, G.N.H.; Rao, J.L.; Gopal, N.O.; Narasimhulu, K.V.; Chakradhar, R.P.S.; Rajulu, A.V. Spectroscopic investigations of Mn2+ ions doped polyvinylalcohol films. Plymer 2004, 45, 5407–5415. [Google Scholar] [CrossRef]
- Pawlak, A.; Mucha, M. Thermogravimetric and FTIR studies of chitosan blends. Thermochim. Acta 2003, 396, 153–166. [Google Scholar] [CrossRef]
- Marsano, E.; Vicini, S.; Skopińska, J.; Wisniewski, M.; Sionkowska, A. Chitosan and poly(vinyl pyrrolidone): Compatibility and miscibility of blends. Macromol. Symp. 2004, 218, 251–260. [Google Scholar] [CrossRef]
- Oliveira, J.M.; Rodrigues, M.T.; Silva, S.S.; Malafaya, P.B.; Gomes, M.E.; Viegas, C.A.; Dias, I.R.; Azevedo, J.T.; Mano, J.F.; Reis, R.L. Novel hydroxyapatite/chitosan bilayered scaffold for osteochondral tissue-engineering applications: Scaffold design and its performance when seeded with goat bone marrow stromal cells. Biomaterials 2006, 27, 6123–6137. [Google Scholar] [CrossRef] [PubMed]
- Li, M.; Cheng, S.; Yan, H. Preparation of crosslinked chitosan/poly(vinyl alcohol) blend beads with high mechanical strength. Green Chem. 2007, 9, 894. [Google Scholar] [CrossRef]
- Li, Y.; Liu, T.; Zheng, J.; Xu, X. Glutaraldehyde-crosslinked chitosan/hydroxyapatite bone repair scaffold and its application as drug carrier for icariin. J. Appl. Polym. Sci. 2013, 130, 1539–1547. [Google Scholar] [CrossRef]
- Coates, J. Interpretation of infrared spectra, a practical approach. Encycl. Anal. Chem. 2000, 12, 10815–10837. [Google Scholar]
- Bernal-Ballén, A.; Kuritka, I.; Saha, P. Preparation and characterization of a bioartificial polymeric material: Bilayer of cellulose acetate-PVA. Int. J. Polym. Sci. 2016, 2016. [Google Scholar] [CrossRef]
- Hussein-Al-Ali, S.H.; El Zowalaty, M.E.; Hussein, M.Z.; Geilich, B.M.; Webster, T.J. Synthesis, characterization, and antimicrobial activity of an ampicillin-conjugated magnetic nanoantibiotic for medical applications. Int. J. Nanomed. 2014, 9, 3801. [Google Scholar] [CrossRef] [PubMed]
- Srinivasa, P.C.; Ramesh, M.N.; Kumar, K.R.; Tharanathan, R.N. Properties and sorption studies of chitosan—Polyvinyl alcohol blend films. Carbohydr. Polym. 2003, 53, 431–438. [Google Scholar] [CrossRef]
- Kumar, H.M.P.N.; Prabhakar, M.N.; Prasad, C.V.; Rao, K.M.; Reddy, T.V.A.K.; Rao, K.C.; Subha, M.C.S. Compatibility studies of chitosan/PVA blend in 2% aqueous acetic acid solution at 30 °C. Carbohydr. Polym. 2010, 82, 251–255. [Google Scholar] [CrossRef]
- Zheng, H.; Du, Y.; Yu, J.; Huang, R.; Zhang, L. Preparation and characterization of chitosan/poly (vinyl alcohol) blend fibers. J. Appl. Polym. Sci. 2001, 80, 2558–2565. [Google Scholar] [CrossRef]
- Bhajantri, R.F.; Ravindrachary, V.; Harisha, A.; Crasta, V.; Nayak, S.P.; Poojary, B. Microstructural studies on BaCl2 doped poly(vinyl alcohol). Polymer 2006, 47, 3591–3598. [Google Scholar] [CrossRef]
- Liang, S.; Yang, J.; Zhang, X.; Bai, Y. The thermal-electrical properties of polyvinyl alcohol/AgNO3 films. J. Appl. Polym. Sci. 2011, 122, 813–818. [Google Scholar] [CrossRef]
- Marciniec, B.; Plotkowiak, Z.; Wachowski, L.; Kozak, M.; Popielarz-Brzezinska, M. Analytical study of β-irradiated antibiotics in the solid state. J. Therm. Anal. Calorim. 2002, 68, 423–436. [Google Scholar]
- Mundargi, R.C.; Shelke, N.B.; Rokhade, A.P.; Patil, S.A.; Aminabhavi, T.M. Formulation and in-vitro evaluation of novel starch-based tableted microspheres for controlled release of ampicillin. Carbohydr. Polym. 2008, 71, 42–53. [Google Scholar] [CrossRef]
- Gonzalez-Campos, J.B.; Prokhorov, E.; Luna-Barcenas, G.; Fonseca-Garcia, A.; Sanchez, I.C. Dielectric relaxations of chitosan: The effect of water on the α-relaxation and the glass transition temperature. J. Polym. Sci. Part B Polym. Phys. 2009, 47, 2259–2271. [Google Scholar] [CrossRef]
- Alhosseini, S.N.; Moztarzadeh, F.; Mozafari, M.; Asgari, S.; Dodel, M.; Samadikuchaksaraei, A.; Kargozar, S.; Jalali, N. Synthesis and characterization of electrospun polyvinyl alcohol nanofibrous scaffolds modified by blending with chitosan for neural tissue engineering. Int. J. Nanomed. 2012, 7, 25. [Google Scholar]
- Cui, Z.; Zheng, Z.; Lin, L.; Si, J.; Wang, Q.; Peng, X.; Chen, W. Electrospinning and crosslinking of polyvinyl alcohol/chitosan composite nanofiber for transdermal drug delivery. Adv. Polym. Technol. 2017, 37, 1917–1928. [Google Scholar] [CrossRef]
- Bonilla, J.; Fortunati, E.; Atarés, L.; Chiralt, A.; Kenny, J.M. Physical, structural and antimicrobial properties of poly vinyl alcohol—Chitosan biodegradable films. Food Hydrocolloids 2014, 35, 463–470. [Google Scholar] [CrossRef]
- Turalija, M.; Bischof, S.; Budimir, A.; Gaan, S. Antimicrobial PLA films from environment friendly additives. Compos. Part. B Eng. 2016, 102, 94–99. [Google Scholar] [CrossRef]
- No, H.K.; Park, N.Y.; Lee, S.H.; Meyers, S.P. Antibacterial activity of chitosans and chitosan oligomers with different molecular weights. Int. J. Food Microbiol. 2002, 74, 65–72. [Google Scholar] [CrossRef]
- Liu, N.; Chen, X.-G.; Park, H.-J.; Liu, C.-G.; Liu, C.-S.; Meng, X.-H.; Yu, L.-J. Effect of MW and concentration of chitosan on antibacterial activity of Escherichia coli. Carbohydr. Polym. 2006, 64, 60–65. [Google Scholar] [CrossRef]
- Tao, Y.; Qian, L.-H.; Xie, J. Effect of chitosan on membrane permeability and cell morphology of Pseudomonas aeruginosa and Staphyloccocus aureus. Carbohydr. Polym. 2011, 86, 969–974. [Google Scholar] [CrossRef]
- Kowalczyk, M.C.; Kowalczyk, P.; Tolstykh, O.; Hanausek, M.; Walaszek, Z.; Slaga, T.J. Synergistic effects of combined phytochemicals and skin cancer prevention in SENCAR mice. Cancer Prev. Res. 2010, 1940–6207. [Google Scholar] [CrossRef] [PubMed]
- López-Garcia, J.; Kuceková, Z.; Humpoliček, P.; Mlček, J.; Sáha, P. Polyphenolic extracts of edible flowers incorporated onto atelocollagen matrices and their effect on cell viability. Molecules 2013, 18, 13435–13445. [Google Scholar] [CrossRef] [PubMed]
- Palmer-Young, E.C.; Sadd, B.M.; Irwin, R.E.; Adler, L.S. Synergistic effects of floral phytochemicals against a bumble bee parasite. Ecol. Evol. 2017, 7, 1836–1849. [Google Scholar] [CrossRef] [PubMed]
- Dutta, P.K.; Tripathi, S.; Mehrotra, G.K.; Dutta, J. Perspectives for chitosan based antimicrobial films in food applications. Food Chem. 2009, 114, 1173–1182. [Google Scholar] [CrossRef]
- Giunchedi, P.; Genta, I.; Conti, B.; Muzzarelli, R.A.A.; Conte, U. Preparation and characterization of ampicillin loaded methylpyrrolidinone chitosan and chitosan microspheres. Biomaterials 1998, 19, 157–161. [Google Scholar] [CrossRef]
- Mitik-Dineva, N.; Wang, J.; Truong, V.K.; Stoddart, P.; Malherbe, F.; Crawford, R.J.; Ivanova, E.P. Escherichia coli, Pseudomonas aeruginosa, and Staphylococcus aureus attachment patterns on glass surfaces with nanoscale roughness. Curr. Microbiol. 2009, 58, 268–273. [Google Scholar] [CrossRef] [PubMed]
- Lynch, A.S.; Robertson, G.T. Bacterial and fungal biofilm infections. Annu. Rev. Med. 2008, 59, 415–428. [Google Scholar] [CrossRef] [PubMed]
- Ma, L.; Gao, C.; Mao, Z.; Zhou, J.; Shen, J.; Hu, X.; Han, C. Collagen/chitosan porous scaffolds with improved biostability for skin tissue engineering. Biomaterials 2003, 24, 4833–4841. [Google Scholar] [CrossRef]
- López-Garcia, J.; Lehocky, M.; Humpoliček, P.; Sáha, P. HaCaT keratinocytes response on antimicrobial atelocollagen substrates: Extent of cytotoxicity, cell viability and proliferation. J. Funct. Biomater. 2014, 5, 43–57. [Google Scholar] [CrossRef] [PubMed]
- Asadinezhad, A.; Novak, I.; Lehocky, M. Polysaccharides coatings on medical-grade PVC: A probe into surface characteristics and the extent of bacterial adhesion. Molecules 2010, 15, 1007–1027. [Google Scholar] [CrossRef] [PubMed]
- Dik, D.A.; Fisher, J.F.; Mobashery, S. Cell-Wall Recycling of the Gram-Negative Bacteria and the Nexus to Antibiotic Resistance. Chem. Rev. 2018, 118, 5952–5984. [Google Scholar] [CrossRef] [PubMed]
- Tenover, F.C. Mechanisms of antimicrobial resistance in bacteria. Am. J. Infect. Control. 2006, 34, S3–S10. [Google Scholar] [CrossRef] [PubMed]
Sample Availability: Samples of the compounds are not available from the authors. |

| Description | Contact Angle (°) | ||
|---|---|---|---|
| Water | Ethylene glycol | Diiodomethane | |
| PVA | <10 * | <10 | 34.93 ± 5.33 |
| CHI | <10 * | <10 | 45.33 ± 1.71 |
| PVA/AMP 0.3% | <10 * | *** | 35.24 ± 4.97 |
| PVA/AMP 1.0% | <10 * | *** | 41.46 ± 3.82 |
| CHI/AMP 0.3% | <10 * | 55.76 ± 4.75 | 45.55 ± 3.34 |
| CHI/AMP 1.0% | <10 * | 47.73 ± 6.54 | 45.56 ± 3.02 |
| PVA/ADD/AMP 0.3% | 61.14 ± 4.13 ** | *** | 22.94 ± 2.00 |
| PVA/ADD/AMP 1.0% | 43.12 ± 1.62 ** | *** | 34.35 ± 2.59 |
| CHI/ADD/AMP 0.3% | <10 * | *** | 45.51 ± 3.45 |
| CHI/ADD/AMP 1.0% | <10 * | *** | 44.24 ± 5.69 |
| PVA/CHI/ADD/AMP 0.3% | 62.43 ± 3.82 ** | 44.36 ± 2.65 | 45.06 ± 2.61 |
| PVA/CHI/ADD/AMP 1.0% | 53.91 ± 2.67 ** | 43.22 ± 1.93 | 51.58 ± 3.88 |
| Sample | Inhibition Zone (mm) Staphylococcus aureus | Inhibition Zone (mm) Escherichia coli |
|---|---|---|
| PVA | - | - |
| CHI | - | - |
| PVA/AMP 0.3% | 2.34 ± 0.69 | - |
| PVA/AMP 1.0% | 3.54 ± 0.60 | 1.26 ± 0.05 |
| * CHI/AMP 0.3% | 3.26 ± 0.87 | - |
| * CHI/AMP 1.0% | 4.36 ± 0.35 | - |
| PVA/ADD/AMP 0.3% | - | 1.27 ± 0.17 |
| PVA/ADD/AMP 1.0% | 1.30 ± 0.17 | 1.13 ± 0.05 |
| * CHI/ADD/AMP 0.3% | 3.61 ± 0.31 | 1.16 ± 0.21 |
| * CHI/ADD/AMP 1.0% | 4.18 ± 0.21 | 1.10 ± 0.16 |
| * PVA/CHI/ADD/AMP 0.3% | 1.18 ± 0.04 | - |
| * PVA/CHI/ADD/AMP 1.0% | 1.20 ± 0.10 | - |
| % AMP | CMAX (μg/g) | −k × 10−3 (1/h) | R2 |
|---|---|---|---|
| PVA/AMP 0.3% | 26.69 ± 0.94 | 43.1 | 0.90 |
| PVA/AMP 1.0% | 70.54 ± 0.71 | 53.8 | 0.90 |
| CHI/AMP 0.3% | 27.11 ± 0.85 | 45.5 | 0.90 |
| CHI/AMP 1.0 % | 75.90 ± 2.09 | 70.5 | 0.90 |
| PVA/ADD/AMP 0.3% | 27.13 ± 0.40 | 0.40 | 0.90 |
| PVA/ADD/AMP 1.0% | 75.60 ± 1.63 * | 0.45 | 0.90 |
| CHI/ADD/AMP 0.3% | 27.12 ± 0.44 | 57.9 | 0.90 |
| CHI/ADD/AMP 1.0% | 73.00 ± 2.16 | 68.7 | 0.95 |
| PVA/CHI/ADD/AMP 0.3% | 78.28 ± 0.23 * | 0.33 | 0.95 |
| PVA/CHI/ADD/AMP 1.0% | 78.74 ± 2.58 * | 0.41 | 0.95 |
© 2018 by the authors. Licensee MDPI, Basel, Switzerland. This article is an open access article distributed under the terms and conditions of the Creative Commons Attribution (CC BY) license (http://creativecommons.org/licenses/by/4.0/).
Share and Cite
Bernal-Ballen, A.; Lopez-Garcia, J.; Merchan-Merchan, M.-A.; Lehocky, M. Synthesis and Characterization of a Bioartificial Polymeric System with Potential Antibacterial Activity: Chitosan-Polyvinyl Alcohol-Ampicillin. Molecules 2018, 23, 3109. https://doi.org/10.3390/molecules23123109
Bernal-Ballen A, Lopez-Garcia J, Merchan-Merchan M-A, Lehocky M. Synthesis and Characterization of a Bioartificial Polymeric System with Potential Antibacterial Activity: Chitosan-Polyvinyl Alcohol-Ampicillin. Molecules. 2018; 23(12):3109. https://doi.org/10.3390/molecules23123109
Chicago/Turabian StyleBernal-Ballen, Andres, Jorge Lopez-Garcia, Martha-Andrea Merchan-Merchan, and Marian Lehocky. 2018. "Synthesis and Characterization of a Bioartificial Polymeric System with Potential Antibacterial Activity: Chitosan-Polyvinyl Alcohol-Ampicillin" Molecules 23, no. 12: 3109. https://doi.org/10.3390/molecules23123109
APA StyleBernal-Ballen, A., Lopez-Garcia, J., Merchan-Merchan, M.-A., & Lehocky, M. (2018). Synthesis and Characterization of a Bioartificial Polymeric System with Potential Antibacterial Activity: Chitosan-Polyvinyl Alcohol-Ampicillin. Molecules, 23(12), 3109. https://doi.org/10.3390/molecules23123109

